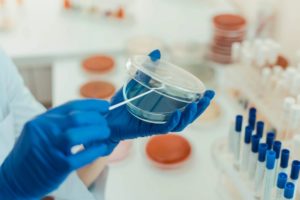

MIPA : un ingrédient indésirable dans les lubrifiants d’usinage
Utilisé dans les lubrifiants d'usinage, le MIPA (MonoIsoPropanolAmine) est une substance classée CMR depuis mars 2025. Le spécialiste des fluides de coupe Blaser Swisslube a engagé un travail de fond pour proposer des solutions alternatives [...]
Lire la suite